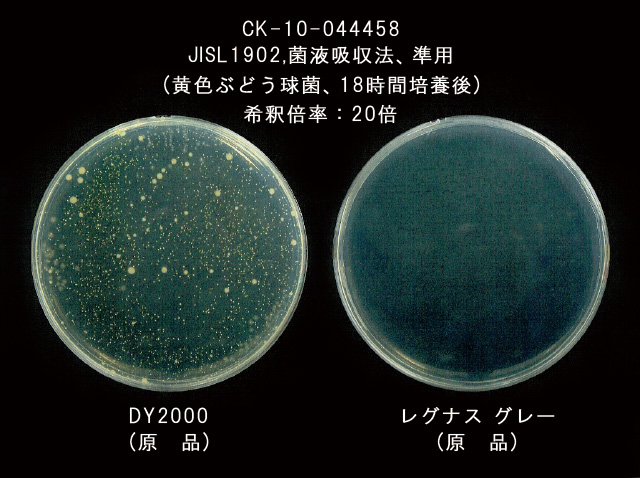
レグナスの特徴

ブリリオ アスリートとは
トップアスリートも愛用するオーダーメイドのインソールです。 競技に合わせた調整が可能です。 オリンピックメダリストやプロ野球、Jリーガー、プロゴルファー、女優、俳優など 多数の実績から生み出される最高のインソールです。 スタビライザー原理と小指の機能改善機能が備わったインソールです。


トップアスリートも愛用するオーダーメイドのインソールです。 競技に合わせた調整が可能です。 オリンピックメダリストやプロ野球、Jリーガー、プロゴルファー、女優、俳優など 多数の実績から生み出される最高のインソールです。 スタビライザー原理と小指の機能改善機能が備わったインソールです。





オーダーメイドインソール『ブリリオ アスリート』は、お一人お一人の足に合わせ、パフォーマンスの向上やケガ予防を鑑みてお作りいたしますので、皆様それぞれ違った形状となります(左右も同じとは限りません)世界に二つとない 貴方だけのインソールが完成いたします。 (写真はサンプルです)

中足骨5 番の骨底部付近に小さなサポートポイント(小指外転ポイント)を付けることで、機能しにくい小指の掴む力を地面に伝え、足指の機能を最大限引き出します。

母趾の屈曲の力を利用し、カーボンファイバーのシートによりクランク機能を働かせ、小指外転ポイントをサポートいたします。親指の屈曲で小指の掴む力を生み出す。まるで車のスタビライザーのような効果が生まれます。
表面材へのこだわり:’TORAY’ の抗菌防臭機能をもった レグナスを使用しています。レグナスは、’TORAY’の独自のポリエステルマイクロファイバーで構成されたナチュラルな表面感と軽さを兼ね備えたスエード調人工皮革です。さらに高いレベルの抗菌防臭性を併せもったニュースエードです。
接着剤へのこだわり:ドイツを初めヨーロッパ各国で規制が厳しくなっている有害なトルエンやメチルエチルケトンを含まない人体や環境に優しいドイツ レニア社製の接着剤を使用しております。

●このライニング材レグナスは東レのせんいを使用しています。
●ソフトでナチュラルな表面感です。
●優れた抗菌防臭機能があります。(検査証明済)
●非常に繊維が細かいので摩擦により、細かな繊維が付着しますが、これは色落ちではありません。粘着テープで除去してください。
表面材はブラック・グレー・ベージュ・ダークベージュ・ワイン の 5色から選択可能。
